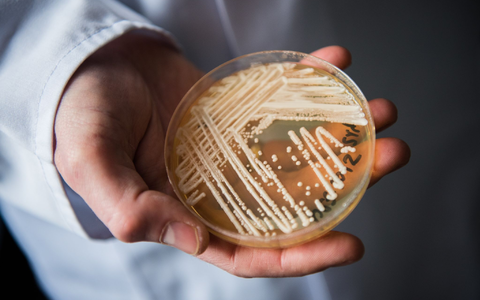
Eine Petrischale mit dem Hefepilz Candida auris. In Deutschland werden immer mehr Fälle des krankmachenden Pilzes bekannt. - Foto: Nicolas Armer/dpa

Der zoonotische Pilz Sporothrix brasiliensis breitet sich ...
Der als Pilz des Jahres gekürte Igelstachelbart gilt als ...

Amethystfarbene Wiesenkoralle ist «Pilz des Jahres». Nun ...
Krankmachender Pilz wird immer öfter nachgewiesen. Gesundheitsbehörden ...